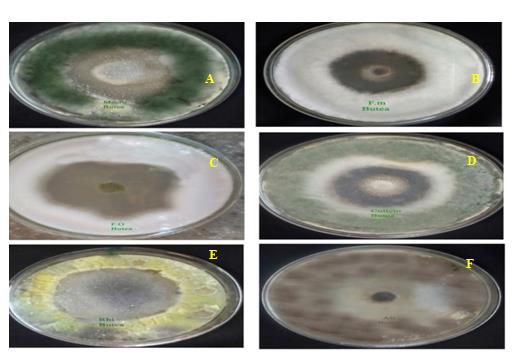

E. Shravya Puri,1 A. Sabitha Rani,2* G. Sulakshana1
1Department of Botany, Osmania University College for Women, Koti, Hyderabad-500095, TS, India
2Department of Botany, University College of Science, Osmania University, Hyderabad-500007, TS, India
*Address for Corresponding author
A.Sabitha Rani
Department of Botany, Osmania University, Hyderabad-500007, TS, India
Abstract
Objective: The leaf extract of Butea monosperma (Lam.) was evaluated in vitro for antifungal activity against six different fungal genera. Material and methods: Different concentration of leaf extract ranging from 500 to 2000 µg was used. All the concentrations exhibited varying degree of inhibition against the test fungi. Higher activity was observed with 2000 µg concentration in all six fungal organisms. Results and conclusion: The zone of inhibition ranged from 0.8cm to 2.6 cm in various fungal species and increased with the increase in the concentration of test solution. Among the test organisms, high inhibition zones were observed in Fusarium oxysporum (2.6 cm) followed by Colletotrichum capsici (1.7cm), Fusarium monoliforme (1.6 cm), Rhizoctonia solani (1.5cm). Among all, Macrophomina phaseolina (0.8 cm) and Alternaria solani (0.9 cm) exhibited lesser activity.
Keywords: Antifungal, Butea monosperma, inhibition zone, Fusarium oxysporum, Colletotrichum capsici, Rhizoctonia solani
Introduction
Higher plants are the rich source for wide variety of biologically active compounds for many centuries and used extensively for treatment of various diseases. Plants possess thousands of useful phytochemicals of great diversity, which have inhibitory effects against the different microorganisms. Till date more than 600 plants have been reported for their potential antimicrobial properties, however a few of them were explored for the active components. The presence of inherent antimicrobial compounds in several higher plants has been recognized as important factors for resistance against diseases. It has been established that extracts of higher plants are the great source of antimicrobial agents against various bacterial and fungal pathogens (Raut et al., 2014).
In recent years, researchers have screened several plant extracts in vitro and in vivo, against plant pathogens and successful results have been achieved. Today, approximately 20% of the plants in the world have been submitted to pharmacological or biological tests for their various biological activities (Suffredini et al., 2004). The rising incidence in multidrug resistance amongst pathogenic microbes has further necessitated the need to search for newer antimicrobial sources from the plant origin.
The screening of plant extracts for their biological activity has an immense significance in development of antimicrobial agents. In vitro evaluation is the primary step in the development of plant based antimicrobial agents. Hence, the study was designed to explore in vitro antifungal potential of Butea monosperma L, a widely distributed perennial tree.
Butea monosperma (Lam.) belongs to the family Fabaceae and commonly known as “Flame of the Forest” (Figure 1). It is a medium sized tree, distributed in tropical and sub-tropical regions of Indian subcontinent. B. monosperma is traditionally used as antitumor, anti-inflammatory, antidiabetic, antimicrobial, diuretic, anthelmintic, astringent carminative (Malpani et al., 2011). Stem of B. monosperma is used in bleeding haemorrhoid disorder, dysmenorrheal, liver disorders, gonorrhoea, wound, worm infections, scorpion sting, cough and cold (Pal et al., 2011). Seed of B. monosperma is used in the treatment of inflammation, urinary stones, abdominal troubles, intestinal worms and tumour. Gum is used in stomatitis, ring worm, leucorrhoea, septic sore throat (Mazumder et al., 2011). The leaves of B. monosperma contain glucoside, kino-oil containing oleic and linoleic acid, palmitic and lignoceric acid (Nadkarni, 2002). The leaf extract posses many medicinal properties and employed in preparation of traditional medicinal formulations. The leaves are also utilized as a packing material. The orange dye obtained from flowers is used in preparation Natural Holi colour and also dyeing the fabric.
In the present work, leaf extract of Butea monosperma was evaluated in vitro for its antifungal activity using Agar cup bioassay.

Figure 1. Butea monosperma plant with flowering (A), Leaves (B) and flowers(C)
Materials and methods
Collection of plant material
Fresh and healthy leaves were collected from the wildly occurring Butea monosperma plants. The leaves were washed thoroughly under running tap water, shade dried and powdered coarsely and used for the preparation of extract.
Preparation of leaf extract
Dried leaf powder of 50 gm was extracted with 500 ml of Petroleum ether (60-80°C) for 8-12 hrs using Soxhlet apparatus. The plant extract was concentrated to dryness with the help of rotary evaporator under reduced pressure. Different concentrations (500-2000 µg) were prepared by dissolving the leaf extract in DMSO (Dimethyl Sulphoxide) and used for in vitro evaluation of antifungal activity.
Test organisms
Six fungal species were used for evaluation of antifungal activity. The fungal pathogens were procured from the Department of Botany, Osmania University, Hyderabad. The fungal organisms used are Fusarium oxysporum, Colletotrichum capsici, Fusarium moniliforme, Alternaria solani, Rhizoctonia solani and Macrophomina phaseolina
Preparation of PDA media and maintenance of fungal cultures
The test organisms were maintained on PDA slants. To prepare the potato dextrose agar (PDA) media, 40 grams of readymade PDA (Hi-media) was dissolved in 900 ml of distilled water, stirred well and made up to one litre with addition of distilled water. The media was then autoclaved at 121°C at 15 psi for 15 min. The fungal cultures were maintained on freshly prepared PDA medium at 25 ± 2° C and three to four replicates were maintained for each treatment.
In vitro screening of leaf extract for antifungal activity
Screening for antifungal activity of leaf extract of Butea monosperma was done by Agar well diffusion technique (Linday, 1962). The Petri dishes were inoculated with seven-day old cultures of selected fungal pathogens. After inoculation, wells were cut out with 10 mm sterile cork borer and the lids of the dishes were replaced. To each well, different concentrations of leaf extract (500μg, 1000μg, 1500μg and 2000μg) were added. Controls were maintained with DMSO and standard antifungal agent, Bavistin (5µg). The treated and control plates were incubated in the incubator at 26°C for 78 hours. Results were noted after the 78 hrs of incubation period by measuring the diameter of the zone of inhibition in centimetres (cm) scale. Three replicates were maintained for each treatment.
Results
In the present study, different concentrations of Butea monosperma leaf extract ranging from 500-2000 µg were employed for antifungal activity. The antifungal activity was observed in all the concentrations of test solution (Figure 2). However, very low activity was observed at 500µg of plant extract in all the fungal members tested. The antifungal potential increased with the increase in concentration of leaf extract. Among all, maximum antifungal activity was observed at 2000µg concentration of leaf extract. Hence, the inhibition zones were measured and compared at this concentration of leaf extract (Table 1).
Table 1. Antifungal activity of Butea monosperma leaf extract
|
Test Fungi |
Concentration of µg |
|||
|
500 |
1000 |
1500 |
2000 |
|
|
Zones of inhibition (cms) |
||||
|
Fusarium monolifarme Alternaria solani Colletotrichum capsici Fusarium oxysporum Rhizoctonia solani Macrophomina phaseolina |
0.6 0.2 0.2 0.3 0.3 0.2 |
0.8 0.4 0.3 0.4 0.6 0.5 |
1.0 0.6 0.5 0.6 0.9 0.7 |
1.6 0.9 1.7 2.6 1.5 0.8 |
Among the test organisms, high inhibition zone was observed in Fusarium oxysporum (2.6cm) followed by Colletotrichum capsici (1.7cm), Fusarium monolifarme (1.6 cm), Rhizoctonia solani (1.5cm). Low inhibition zones were observed in Macrophomina phaseolina (0.8cm) and Alternaria solani (0.9 cm) (Figure 3).
Figure 2. Antifungal activity of leaf extract of Butea monosperma against six fungal species

Figure 3. Antifungal activity of Butea monosperma leaf extract
Discussion
The results showed that the leaf extract of Butea monosperma exhibited antimicrobial activity against different plant pathogens. Among all, high fungal inhibition was observed at 2000 µg concentration of leaf extract. Among the fungi, high inhibition zones were observed in Fusarium oxysporum followed by Colletotrichum capsici. Moderate activity was noticed against Fusarium monolifarme and Rhizoctonia solani. The activity was low in Macrophomina phaseolina and Alternaria solani. Similar result was reported in studies on the flower extract of Spilanthes acmella (Sabitha and Murty, 2006). Daru and Chauhan (2016) also reported significant inhibitory action against bacterial and fungal strains using Butea monosperma leaf extracts. Similarly, antifungal activity of many medicinal plants against the several pathogenic fungi was reported (Al-Shahwany et al., 2021).
Conclusion
In the present study, B. monosperma leaf extract was found capable of reducing growth of fungi in in vitro conditions. All the organisms which are employed in the present study are pathogenic fungi causing several diseases of plants. These preliminary results can be further supplemented by in vivo studies, both in greenhouse and in open field conditions. Hence, the antifungal potential of Butea monosperma can be exploited in development of plant based fungicides to control many important plant diseases.
References
Al-Shahwany AW, Nijam A, Shoker RMH. 2021. Antifungal activity of oils extracted from certain medicinal plants against selected fungi. Plant Cell Biotechnology and Molecular Biology, 22(37-38):229-241.
Daru S, Chauhan PB. 2016. Evaluation of Biological Activity of Butea Monosperma and Tectona grandis leaf extract. International Journal of Research and Scientific Innovation, 3 (5):49-53.
Linday EM. 1962. Practical introduction to Microbiology. London: E and FN Spon Ltd; 1962. p. 177
Malpani MO, Rajput PR, Mane VD, Dhabe PS. 2011. Phytochemical screening, antifungal activity and curative impact on Channa punctatus fish by B. monosperma (LAM) flower, leaves and gum. Der Pharmacia Lettre, 3(5):271-280.
Mazumder PM, Das MK, Das S. 2011. Butea monosperma (LAM.) Kuntze- a comprehensive review. International Journal of Pharmaceutical Sciences and Nanotechnology, 4(2):1390-1393.
Nadkarni KM. 2002. Indian Materia Medica (Bombay Popular Prakashan) 1:223-225 (Pal, P and Bose, S. 2011). Phytopharmacological and Phytochemical Review of Butea monosperma Lam. International Journal of Research in Pharmaceutical and Biomedical Sciences, 2(3):1374-1388
Raut JS, Karuppayil SM. 2014. A status review on the medicinal properties of essential oils. Industrial Crops and Products, 62:250–264.
Rani S, Murthy USN A. 2006. Antifungal potential of flower head extract of Spilanthes acmella, an important plant of Asteraceae. African Journal of Biomedical Research, 9:67-68.
Suffredini IB, Sader HS, Gonçalves AG, Reis AO, Gales AC, Varella AD, Younes RN. 2004. Screening of antibacterial active extracts obtained from plants native to Brazilian Amazon rain forest and Atlantic forest. The Brazilian Journal of Medical and Biological Research, 37:379–384.